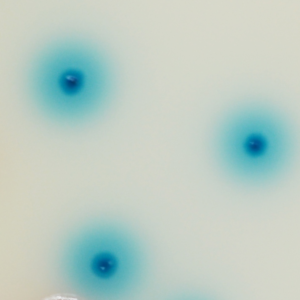

Description
Colonies Appearance


Acinetobacter spp.
red

Other Gram (-)
blue or mostly inhibited
Performance
Common bacteria widely spread in the nature, Acinetobacter has the capacity to survive in dry as well as moist environments. It becomes a source of infection in hospital environment when colonizing medical equipments, human skin and sometimes foodstuff. Acinetobacter species are generally not pathogenic for healthy people but are life threatening in compromised patients. It is often isolated in nosocomial infections cases, intensive care units, and can for instance cause nosocomial pneumonia, bacteraemia, and meningitis.
Especially, Acinetobacter baumannii is becoming a major hospital-acquired infection issue because of its often multi-drug resistance (MDR : resistance to C3G, quinolones, carbapenems, etc). This contributes to the increase of morbidity and mortality.
Active surveillance is necessary to control its spread in the facilities, to reduce the risk of cross-contamination, and to identify the carriers. Rapid identification of patients that are colonized with Acinetobacter would lead to infection control practices aimed at preventing spread of the organisms.
Intended Use
CHROMagar™ Acinetobacter is a selective and differential chromogenic culture medium, intended for use in the qualitative direct detection of colonization with Acinetobacter to aid in the prevention and control of Acinetobacter, drug-susceptible or multi-drug resistant (MDR), in healthcare settings. The test is performed with rectal swabs, nare swabs, wound swabs, stools and urine samples from patients to screen for Acinetobacter colonization. It can also be used in hygiene monitoring in the clinical environment with surface sampling. Results can be interpreted after 18-24 h of aerobic incubation at 35-37 °C.
The medium can also be used as an early warning indicator for diagnostic tests of infections to signal the possible presence of multi drug-resistant bacteria. This use does not replace the institution’s protocols.
CHROMagar™ Acinetobacter is not intended to diagnose Acinetobacter infection nor to guide nor monitor treatment for infections. A lack of growth or the absence of colonies on CHROMagar™ Acinetobacter does not preclude the presence of Acinetobacter. Further identification, susceptibility testing, and epidemiological typing is needed on suspect colonies.
1. Unique red colour : Detection of A. baumannii from traditional culture media might be a difficult and tedious task due to the abundance of background flora found in collected specimens, especially when using media based on differentiation by the lactose/non-lactose fermentation ability. To overcome these difficulties, CHROMagar™ Acinetobacter was designed as a highly selective medium, allowing the growth of Acinetobacter in conspicuously red colonies, after overnight incubation.


2. Unique chromogenic medium for Acinetobacter detection.
3. Screening of MDR Acinetobacter : This medium can be supplemented to enhance MDR specificity allowing the growth of carbapenem-resistant strains.
Composition










